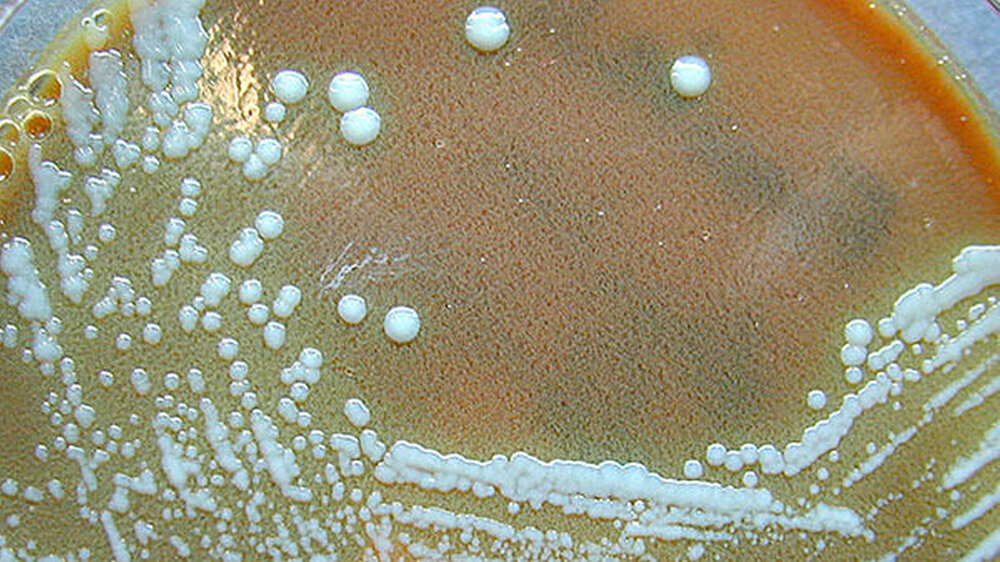

Tularämie beginnt im Mund
Es kann im Rachen oder auf der Mundschleimhaut beginnen, mit Efloreszenzen oder mit Grippe ähnlichen Symptomen, daher sollten auch Zahnärzte wissen, dass die humane Tularämie - auch "Hasenpest" genannt - auch auf den Menschen übertragen werden kann.
Die häufig tödlich verlaufende, hoch ansteckende Erkrankung kommt vorwiegend bei frei lebenden Nagetieren und Hasen vor und wird durch das Bakterium Francisella tularensis ausgelöst. Die Erkrankung kann als sogenannte Zoonose auf den Menschen übertragen werden und zählt in Deutschland zu den meldepflichtigen Tierkrankheiten.
Mehr Artikel zum Thema Infektionskrankheiten finden Sie hier auf der Themenseite
Das Robert-Koch-Institut geht davon aus, dass die tatsächlichen Fallzahlen weitaus höher liegen, als derzeit durch Meldungen bekannt. In Europa wurden in den vergangenen Jahren zwischen 500 und 1.000 Fälle jährlich gemeldet. Betroffen sind häufig Personen, die sich viel in der freien Natur aufhalten, wie Jäger und Waldarbeiter.
Infektionsweg durch Hasen, Kaninchen und Nager
Der Erreger infiziert vorwiegend Kleinsäuger wie Hasen, Kaninchen und Mäuse, aber auch andere Wild- und auch Haustiere. Darüber hinaus wurde er bei blutsaugenden Arthropoden wie Bremsen, Mücken und Zecken, aber auch in Vögeln und Amphibien nachgewiesen.
F. tularensis findet sich zudem auch in der Umwelt - im Wasser sowie der Erde. Auf die Anwesenheit des Erregers wird häufig nur durch einen DNA-Nachweis geschlossen, da seine Anzucht sehr schwierig ist. Das natürliche Reservoir ist bisher nicht eindeutig detektiert.
Die Infektion kann erfolgen durch:
Kontakt der Haut oder Schleimhäute mit infektiösem Tiermaterial (wie bei der Verarbeitung infizierter Tiere) oder mit kontaminiertem Wasser; in der Folge auch durch Schmierinfektionen, zum Beispiel der Infektion der Augen durch Kontakt mit kontaminierten Händen.
Verzehr von nicht ausreichend erhitztem, kontaminiertem Fleisch (Hasen) oder anderen kontaminierten Lebensmitteln (auch durch Mäusekot kontaminiertes Getreide).
Aufnahme von kontaminiertem Wasser.
Inhalation von kontaminiertem Staub oder Aerosolen (wie beim industriellen Waschen und Zerkleinern von kontaminiertem Gemüse, Rasenmähen oder Heuverarbeiten.
Stich oder Biss von infizierten blutsaugenden Arthropoden (so auch von Bremsen, Mücken, Zecken).
Eine Mensch-zu-Mensch-Übertragung ist nicht bekannt. Aber auf Grund der hohen Infektiosität besteht ein erhöhtes Risiko für Laborinfektionen. Wegen der erforderlichen geringen Infektionsdosis des Erregers in Geweben und Körperflüssigkeiten von Erkrankten (über einen Ulcus der Haut oder auch im Sputum von Erkrankten ist eine Mensch-zu-Mensch-Übertragung nicht auszuschließen und auch in der Zahnarztpraxis - wenn auch sehr selten - möglich.
Die Inkubationszeit ist abhängig von der Infektionsdosis sowie dem Infektionsweg und kann zwischen einem bis 14 Tage betragen, meistens sind es aber drei bis fünf Tage.
###more### ###title### Klinische Symptomatik ###title### ###more###
Klinische Symptomatik
Häufig treten grippeähnliche Symptome wie Fieber, Lymphknotenschwellungen, Schüttelfrost, Unwohlsein sowie Kopf- und Gliederschmerzen auf. In Abhängigkeit von der Eintrittspforte des Erregers in den Organismus werden folgende Erkrankungsformen unterschieden:
Ulzeroglandulär und glandulär (nach Hautkontakt mit den Erregern, auch ohne vorhandene Wunden oder offene Hautstellen, inklusive Arthropodenbiss/-stich): Bildung einer primären Ulzeration (häufig zunächst unentdeckt, Größe von wenigen Millimetern bis wenigen Zentimetern; bildet sich kein Ulcus, so liegt die glanduläre Form vor), regionale Lymphknotenschwellung (bei spätem Behandlungsbeginn vereiternd und nekrotisierend).
Oculoglandulär (nach Infektion des Auges, z.B. durch Wischen mit der kontaminierten Hand): meist einseitige Konjunktivitis mit Ödemen am Lid oder starkem Tränenfluss, Lichtempfindlichkeit, regionale Lymphknotenschwellung.
Oropharyngeal (nach Aufnahme von kontaminiertem Wasser oder Lebensmitteln): meist einseitige, oft massive submandibuläre und zervikale Lymphknotenschwellung, Stomatitis, Pharyngitis, Tonsillitis möglich; bei hohen Dosen ist eine gastrointestinale Beteiligung mit Bauchschmerzen, Erbrechen und Durchfall nicht ausgeschlossen.
Pulmonal (nach Inhalation der Erreger): Bronchopneumonie, Husten, Brustschmerzen, Atemstörungen und Atemnot, Schweißausbrüche, Übelkeit, Erbrechen, hiläre Lymphknotenschwellung; eine Pneumonie kann, muss aber nicht vorkommen.
Komplikationen und krankheitsverlauf
Als Komplikationen von Infektionen mit dem Subtyp tularensis können sekundäre Pneumonien, schwere Septikämie, Endokarditis, Leber- und Nierenversagen auftreten. Bei Infektionen mit dem Subtyp holarctica sind gelegentlich Meningitis und Sepsis zu beobachten; Pneumonien sind eher selten. Bei beiden Subtypen können Hauterscheinungen wie Erythema nodosum und Erythema multiforme auftreten.
In Abhängigkeit von der Subspezies, dem Übertragungsweg, der aufgenommenen Erregermenge und dem Zeitpunkt des Beginns einer gezielten Therapie gibt es eher milde oder sehr schwere Krankheitsverläufe. Bei rechtzeitiger, adäquater Therapie treten nur selten Todesfälle auf. Die pulmonale Infektion mit F. tularensis ssp. tularensis kann unbehandelt in 30 bis 60 Prozent der Fälle zum Tod führen. Bei Infektionen mit dem in Europa auftretenden Subtyp holarctica kommt es oft zur Spontanheilung; Todesfälle sind, auch ohne Behandlung, sehr selten.
###more### ###title### Dauer der Ansteckungsfähigkeit ###title### ###more###
Dauer der Ansteckungsfähigkeit
Eine Mensch-zu-Mensch-Übertragung ist nicht bekannt. Mit dem Erreger kontaminierte Materialien bleiben bei Temperaturen zwischen 0°C und 10°C wochenlang, bei Temperaturen unter dem Gefrierpunkt monatelang lebensfähig. Mit dem Erreger kontaminierte Materialien in der Umwelt (wie Wasser, Kadaver erkrankter Tiere) bleiben insbesondere in den kalten Wintermonaten lange infektiös. Gefrorenes kontaminiertes Fleisch bleibt monatelang infektiös.
Die Diagnostik ist ausschließlich eine Differenzialdiagnostik
Auf Grund des unspezifischen und vielfältigen klinischen Bildes kommt differenzialdiagnostisch eine Reihe von Krankheiten in Betracht. Dazu gehören die Brucellose, Influenza, Katzenkratzkrankheit, Legionellose, Mykobakteriosen, Q-Fieber, Pest, Staphylokokken- und Streptokokkeninfektionen und Syphilis. Eine ausführliche Liste der Differentialdiagnosen findet sich auch in den WHO Guidelines on Tularaemia, Seite 17-19 (WHO 2007).
Therapie
Um einen schweren Krankheitsverlauf und Komplikationen zu vermeiden, ist eine frühzeitige Therapie essentiell. Wirksam gegen F. tularensis sind Aminoglycoside, Fluorchinolone, Tetracycline, Chloramphenicol und Rifampicin. Penicilline und andere Beta-Lactam-Antibiotika sind wirkungslos. Vor Ausschluss von Resistenzen sollte die Behandlung nicht mit Makrolidantibiotika erfolgen.Ausführliche Hinweise zur Therapie der Tularämie gibt der Ständige Arbeitskreis der Kompetenz- und Behandlungszentren für hochkontagiöse und lebensbedrohliche Erkrankungen (STAKOB).
Mehr Artikel zum Thema Infektionskrankheiten finden Sie hier auf der Themenseite
Quellen:Epidemiologisches Bulletin 41/2016 Robert-Koch-Institut, homepageWHO Guidelines on Tularaemia, Seite 17-19 (WHO 2007).